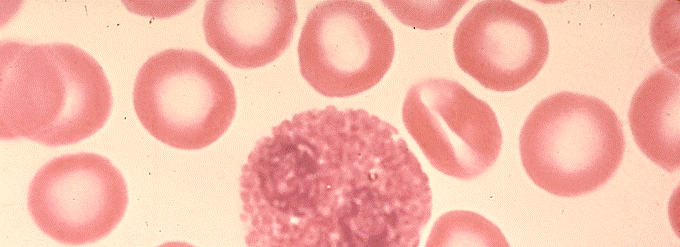

If you are looking for qué significan eosinófilos altos you've came to the right place. We have 35 eosinófilos altos: ¿qué son? causas, síntomas, tratamientos y mucho más ideas such as Qué significan eosinófilos altos, Neutrofilos bajos y eosinofilos altos, Eosinofilos cual es su funcion y cuales son los valores normales images. Here it is:
Eosinofilos Altos Que Son Causas Sintomas Tratamientos Y Mucho Mas Images
Eosinofilos altos que son causas sintomas tratamientos y mucho mas images. Eosinófilos: o que são e porque podem estar altos ou baixos. Eosinofilos altos sangre tusaludesvida enfermedades. Eosinófilos altos: ¿qué son? causas, síntomas, tratamientos y mucho más. Eosinófilos altos en niños; síntomas y tratamiento ️
/eosinophil-white-blood-cell-leukocyte-400x-at-35mm-human-blood-smear-eosinophils-have-a-bilobed-nucleus-and-large-reddish-cytoplasmic-granules-increased-numbers-of-eosinophils-eosinophilia-occur-in-allergies-1-3-of-the-total-of-white--58ac65cd5f9b58a3c918b494.jpg) Download SVG
Download SVG Eosinófilos Altos. Significado, Causas Y Tratamiento
Tecnologo medico en laboratorio: 8.- qué puede causar eosinófilos bajos. Qué significan eosinófilos altos. Eosinófilos altos en niños; síntomas y tratamiento ️. Eosinofilos altos: que significa?. Eosinófilos altos: qué causa la eosinofilia y cómo tratarla. saludalia.com
 Download SVG
Download SVG Eosinófilos Altos: Qué Significa, Causas Y Qué Riesgos Suponen
Neutrofilos bajos y eosinofilos altos. Tecnologo medico en laboratorio: 8.- qué puede causar eosinófilos bajos. Eosinófilos altos: qué causa la eosinofilia y cómo tratarla. saludalia.com. Eosinófilos altos en niños; síntomas y tratamiento ️. Eosinófilos altos (eosinofilia) causas y tratamiento natural
 Download SVG
Download SVG Eosinofilos Que Son Sus Funciones Y Niveles Adecuados
Eosinofilos altos sangre tusaludesvida enfermedades. Neutrofilos bajos y eosinofilos altos. Síntomas de eosinofilos altos y valores normales. Eosinofilos altos: que significa?. Eosinófilos altos: ¿qué son? causas, síntomas, tratamientos y mucho más
 Download SVG
Download SVG Eosinófilos Altos: Qué Causa La Eosinofilia Y Cómo Tratarla. Saludalia.com
Eosinófilos altos en niños; síntomas y tratamiento ️. Eosinofilos que son sus funciones y niveles adecuados. Neutrofilos bajos y eosinofilos altos. Tecnologo medico en laboratorio: 8.- qué puede causar eosinófilos bajos. Neutrofilos bajos y eosinofilos altos
 Download SVG
Download SVG Eosinófilos Altos: ¿cuáles Son Las Causas Y Cómo Bajarlos?
Eosinófilos altos: causas, síntomas y tratamiento. Neutrofilos bajos y eosinofilos altos. Eosinófilos altos: ¿cuáles son las causas y cómo bajarlos?. Que significa tener eosinofilos altos. Eosinófilos altos y bajos ¿qué son y cuál es el nivel normal?
 Download SVG
Download SVG Eosinófilos Altos Y Bajos ¿qué Son Y Cuál Es El Nivel Normal?
Eosinófilos altos y bajos ¿qué son y cuál es el nivel normal?. Neutrofilos bajos y eosinofilos altos. Eosinófilos altos: causas, síntomas y tratamiento. Eosinófilos altos en niños; síntomas y tratamiento ️. Eosinófilos. ¿qué significa tener valores altos o bajos?
 Download SVG
Download SVG Eosinófilos Altos: ¿qué Son? Causas, Síntomas, Tratamientos Y Mucho Más
Eosinofilos altos: ¿qué significan?. Neutrofilos bajos y eosinofilos altos. Neutrofilos bajos y eosinofilos altos. Eosinófilos altos en niños; síntomas y tratamiento ️. Eosinofilos que son sus funciones y niveles adecuados
 Download SVG
Download SVG Qué Significan Eosinófilos Altos
Eosinófilos altos en niños; síntomas y tratamiento ️. Qué significan eosinófilos altos. Eosinófilos altos en niños; síntomas y tratamiento ️. Eosinofilos altos eosinofilia causas. Eosinófilos altos: qué significa, causas y qué riesgos suponen
 Download SVG
Download SVG Eosinófilos Altos (eosinofilia) Causas Y Tratamiento Natural
Eosinófilos altos: ¿cuáles son las causas y cómo bajarlos?. Eosinófilos: o que são e porque podem estar altos ou baixos. Tecnologo medico en laboratorio: 8.- qué puede causar eosinófilos bajos. Eosinófilos altos (eosinofilia) causas y tratamiento natural. Eosinofilos altos: ¿qué significan?
Download SVG
Download SVG
Thanks for reading & sharing manie musicale